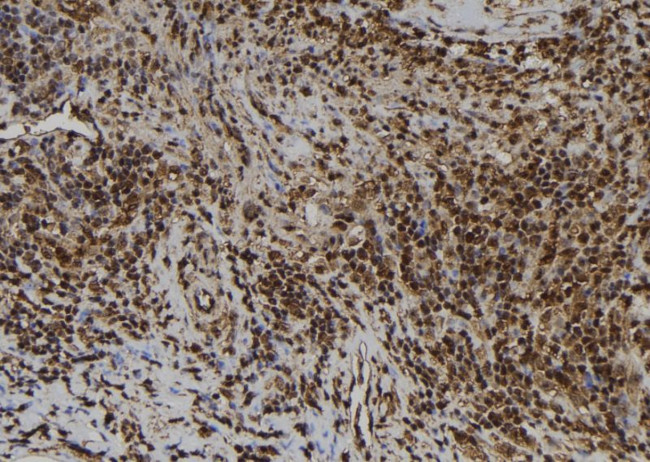
EMAP II Antibody in Immunohistochemistry (Paraffin) (IHC (P))

Search
Invitrogen
EMAP II Polyclonal Antibody
{{$productOrderCtrl.translations['antibody.pdp.commerceCard.promotion.promotions']}}
{{$productOrderCtrl.translations['antibody.pdp.commerceCard.promotion.viewpromo']}}
{{$productOrderCtrl.translations['antibody.pdp.commerceCard.promotion.promocode']}}: {{promo.promoCode}} {{promo.promoTitle}} {{promo.promoDescription}}. {{$productOrderCtrl.translations['antibody.pdp.commerceCard.promotion.learnmore']}}
图: 1 / 2
EMAP II Antibody (PA5-102719) in IHC (P)


Please note: We are reviewing Western blot images included in the antibody testing data in our catalog, including those provided by third parties. Unless expressly labeled or annotated as “raw-unedited”, Western blot images included in the antibody testing data in our catalog may have been edited, optimized or otherwise adjusted for presentation.
产品信息
PA5-102719
种属反应
宿主/亚型
分类
类型
抗原
偶联物
形式
浓度
规格
纯化类型
保存液
内含物
保存条件
运输条件
RRID
产品详细信息
Antibody detects endogenous levels of total AIMP1.
靶标信息
The protein encoded by this gene is a cytokine that is specifically induced by apoptosis, and it is involved in the control of angiogenesis, inflammation, and wound healing. The release of this cytokine renders the tumor-associated vasculature sensitive to tumor necrosis factor. The precursor protein is identical to the p43 subunit, which is associated with the multi-tRNA synthetase complex, and it modulates aminoacylation activity of tRNA synthetase in normal cells. This protein is also involved in the stimulation of inflammatory responses after proteolytic cleavage in tumor cells. Multiple transcript variants encoding different isoforms have been found for this gene. A pseudogene has been identified on chromosome 20.
仅用于科研。不用于诊断过程。未经明确授权不得转售。
篇参考文献 (0)
生物信息学
蛋白别名: Aminoacyl tRNA synthase complex-interacting multifunctional protein 1; ARS inducible multifunctional protein 1; ARS-interacting multifunctional protein 1; endothelial monocyte activating polypeptide 2; endothelial monocyte-activating polypeptide 2; endothelial-monocyte activating polypeptide II; mca1; Multisynthase complex auxiliary component p43; multisynthetase complex auxiliary component p43; SCYE1; small inducible cytokine subfamily E, member 1; small inducible cytokine subfamily E, member 1 (endothelial monocyte-activating); unnamed protein product
基因别名: 9830137A06Rik; AIMP1; AIMP1/p43; EMAP2; EMAPII; HLD3; p43; SCYE1
UniProt ID: (Mouse) P31230
Entrez Gene ID: (Human) 9255, (Mouse) 13722, (Rat) 114632